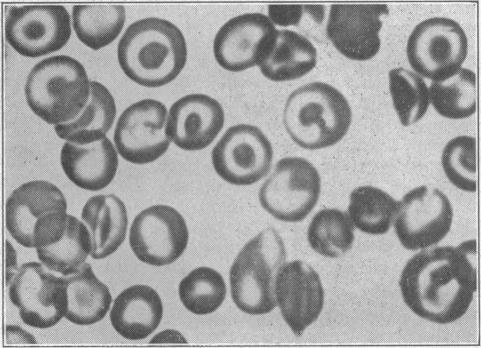
https://cdn.ncbi.nlm.nih.gov/pmc/blobs/c009/1973970/ea2c52efad5b/brmedj03136-0038-a.jpg

Haemoglobin C disease and trait; report of a family in England with haemoglobin C.
作者信息
RICE H M
出版信息
Br Med J. 1957 Jan 5;1(5009):25-7. doi: 10.1136/bmj.1.5009.25.
Abstract
摘要
相似文献
1
Haemoglobin C disease and trait; report of a family in England with haemoglobin C.
Br Med J. 1957 Jan 5;1(5009):25-7. doi: 10.1136/bmj.1.5009.25.
2
Haemoglobin c in arabs in kuwait.
Acta Haematol. 1973;50(2):112-5. doi: 10.1159/000208337.
3
Homozygous hemoglobin C disease; report of a case with studies on the pathophysiology and neonatal formation of hemoglobin C.
Am J Med. 1955 May;18(5):832-8. doi: 10.1016/0002-9343(55)90195-9.
4
INTRAERYTHROCYTIC HEMOGLOBIN CRYSTALS IN SICKLE CELL-HEMOGLOBIN C DISEASE.
Blood. 1965 Feb;25:218-23.
5
[First case of hemoglobin C-thalassemia in Italy].
Boll Soc Ital Biol Sper. 1960 Feb 15;36:93-6.
6
Hereditary persistence of foetal haemoglobin: a family study suggesting allelism of the F gene to the S and C haemoglobin genes.
Br J Haematol. 1961 Jul;7:373-81. doi: 10.1111/j.1365-2141.1961.tb00347.x.
7
Genetics of haemoglobin.
Guys Hosp Rep. 1967;116(3):307-22.
8
[The hemoglobins. I. Structure of the normal and abnormal hemoglobins].
Presse Med (1893). 1968 Mar 2;76(11):519-21.
9
Haemoglobin C in a Spanish family.
Br Med J. 1969 May 31;2(5656):574. doi: 10.1136/bmj.2.5656.574.
10
Homozygous haemoglobin-C disease in a white family with special reference to blood autolysis studies.
Br J Haematol. 1957 Jan;3(1):68-76. doi: 10.1111/j.1365-2141.1957.tb05772.x.
本文引用的文献
1
Sickle cell anemia a molecular disease.
Science. 1949 Nov 25;110(2865):543-8. doi: 10.1126/science.110.2865.543.
2
A new inherited abnormality of human hemoglobin.
Proc Natl Acad Sci U S A. 1950 Nov;36(11):613-7. doi: 10.1073/pnas.36.11.613.
3
Some characteristic properties of hemoglobin C.
Blood. 1955 Nov;10(11):1079-91.
4
Intraerythrocytic crystals in a white patient with hemoglobin C in the absence of other types of hemoglobin.
Blood. 1954 Dec;9(12):1172-84.
5
Homozygous hemoglobin C; a new hereditary hemolytic disease.
N Engl J Med. 1954 Sep 2;251(10):365-73. doi: 10.1056/NEJM195409022511001.
6
A case of sickle cell; haemoglobin C disease and a survey of haemoglobin C incidence in West Africa.
Trans R Soc Trop Med Hyg. 1954 Jul;48(4):332-6. doi: 10.1016/0035-9203(54)90104-2.
7
Homozygous type c hemoglobin.
Pediatrics. 1953 Nov;12(5):483-90.
8
Filter paper electrophoresis of human hemoglobins with special reference to the incidence and clinical significance of hemoglobin C.
Bull Johns Hopkins Hosp. 1953 Aug;93(2):94-106.